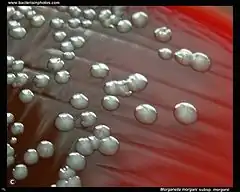
Description de cette image, également commentée ci-après

Morganellaceae
Morganella
Morganella (ici M. morganii sur gélose au sang) est le genre type de la famille des Morganellaceae.
| Domaine | Bacteria |
|---|---|
| Embranchement | Proteobacteria |
| Classe | Gammaproteobacteria |
| Ordre | Enterobacterales |
Famille
Les Morganellaceae sont une famille de bacilles Gram négatifs de l'ordre des Enterobacterales. Leur nom provient de Morganella qui est le genre type de la famille.
Systématique
Cette famille a été créée en 2016 lors de la réorganisation de l'ordre des Enterobacterales par Mobolaji Adeolu (d) et al. sur la base de travaux de phylogénétique moléculaire[1]. Les genres bactériens qui la composent étaient auparavant rattachés aux Enterobacteriaceae par des critères phénotypiques.
Liste de genres
Selon la LPSN[2] (17 juin 2021) :
- Arsenophonus Gherna et al., 1991
- Cosenzaea Giammenco et al., 2011
- Moellerella Hickman-Brenner et al., 1984
- Morganella Fulton, 1943 - genre type
- Photorhabdus Boemare et al., 1993
- Proteus Hauser, 1885
- Providencia Ewing, 1962
- Xenorhabdus Thomas & Poinar, 1979
Publication originale
- (en) Mobolaji Adeolu, Seema Alnajar, Sohail Naushad et Radhey S. Gupta, « Genome-based phylogeny and taxonomy of the 'Enterobacteriales': proposal for Enterobacterales ord. nov. divided into the families Enterobacteriaceae, Erwiniaceae fam. nov., Pectobacteriaceae fam. nov., Yersiniaceae fam. nov., Hafniaceae fam. nov., M », International Journal of Systematic and Evolutionary Microbiology, Society for General Microbiology (d), vol. 66, no 12, , p. 5575-5599 (ISSN 1466-5026 et 1466-5034, OCLC 807119723, PMID 27620848, DOI 10.1099/IJSEM.0.001485, lire en ligne).
Notes et références
- ↑ Adeolu et al. 2016, p. 5594
- ↑ https://lpsn.dsmz.de/family/morganellaceae, consulté le 17/06/21.
Liens externes
- (en) NCBI : Morganellaceae (taxons inclus) (consulté le )
- Portail de la microbiologie
Cet article est issu de Wikipedia. Le texte est sous licence Creative Commons – Attribution – Partage à l’identique. Des conditions supplémentaires peuvent s’appliquer aux fichiers multimédias.